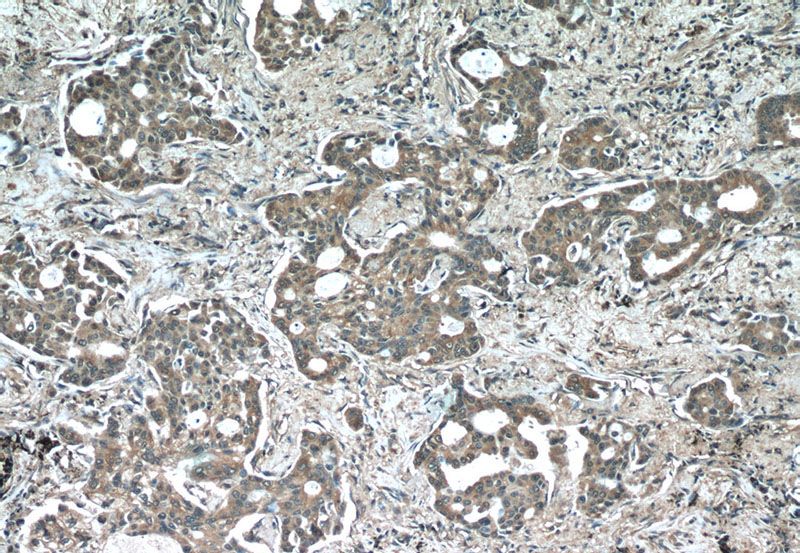
Immunohistochemistry of paraffin-embedded human lung cancer tissue slide using Catalog No:107557(TUBA1A(ace-40Lys) Antibody) at dilution of 1:50 (under 10x lens)

-
Product Name
acetylated Tubulin (Lys40) antibody
- Documents
-
Description
acetylated Tubulin (Lys40) Mouse Monoclonal antibody. Positive IF detected in MDCK cells. Positive IHC detected in human lung cancer tissue, human gliomas tissue. Positive WB detected in L02 cells. Observed molecular weight by Western-blot: 55 kDa
-
Tested applications
ELISA, WB, IHC, IF
-
Species reactivity
Human, Mouse, Rat, Dog; other species not tested.
-
Alternative names
acetylated alpha tubulin antibody; Acetylated tubulin antibody; acetylated-a-tubulin antibody; acetyl-a-tubulin antibody; alpha tubulin antibody; Alpha tubulin 3 antibody; tubulin antibody
-
Isotype
Mouse IgG1
-
Preparation
This antibody was obtained by immunization of Peptide (Accession Number: NM_006009). Purification method: Protein G purified.
-
Clonality
Monoclonal
-
Formulation
PBS with 0.02% sodium azide and 50% glycerol pH 7.3.
-
Storage instructions
Store at -20℃. DO NOT ALIQUOT
-
Applications
Recommended Dilution:
WB: 1:500-1:5000
IHC: 1:20-1:200
IF: 1:20-1:200
-
Validations

Immunofluorescent analysis of MDCK cells using Catalog No:107557(TUBA1A(ace-40Lys) Antibody) at dilution of 1:50 and Alexa Fluor 488-congugated AffiniPure Goat Anti-Mouse IgG(H+L)

L02 cells were subjected to SDS PAGE followed by western blot with Catalog No:107557(TUBA1A(ace-40Lys) Antibody) at dilution of 1:1000
Immunohistochemistry of paraffin-embedded human lung cancer tissue slide using Catalog No:107557(TUBA1A(ace-40Lys) Antibody) at dilution of 1:50 (under 10x lens)

Immunohistochemistry of paraffin-embedded human lung cancer tissue slide using Catalog No:107557(TUBA1A(ace-40Lys) Antibody) at dilution of 1:50 (under 40x lens)

Immunofluorescent analysis of MDCK cells using Catalog No:107557(TUBA1A(ace-40Lys) Antibody) at dilution of 1:100 and Alexa Fluor 488-congugated AffiniPure Goat Anti-Mouse IgG(H+L)

Immunofluorescent images of MDCK cells stained for IFT88 rabbit pAb (Catalog No:111674) and acetylated tubulin mouse mAb (Catalog No:107557) at dilution of 1:50, further stained with Alexa Fluor 594-congugated AffiniPure Goat Anti-Rabbit IgG (H+L) for Catalog No:111674, and Alexa Fluor 488-congugated AffiniPure Goat anti-Mouse IgG (H+L) for Catalog No:107557.
-
Background
Tubulin, composed of heterodimers of alpha and beta tubulin, is the mainly component of microtubules which play important roles in cell motility, mitosis, and intracellular vesicle transport. Both alpha and beta tubulin undergo several posttranslational modifications such as polyglutamylation and acetylation/deacetylation. Tubulin acetylation occurs on lysine-40 at the N-terminal of alpha tubulin and is conserved across species. The histone deacetylase HDAC6 and SIRT2 has been identified as tubulin deacetylases. Reversible acetylation of alpha tubulin may be implicated in regulating microtubule stability, cell motility, and axon regeneration. The level of acetylated tubulin has been linked to epithelial malignancies and sensitivity to chemotherapy. In addition, acetylated tubulin has been widely used as a marker for primary cilia. This antibody is specific to the acetylated tubulin; it does not recognize non-acetylated tubulin. (24268707, 23881549)
-
References
- Li L, Liu B, Zhang X, Ye L. The oncoprotein HBXIP promotes migration of breast cancer cells via GCN5-mediated microtubule acetylation. Biochemical and biophysical research communications. 458(3):720-5. 2015.
- Chen T, Wu Q, Zhang Y, Zhang D. NDUFV2 regulates neuronal migration in the developing cerebral cortex through modulation of the multipolar-bipolar transition. Brain research. 1625:102-10. 2015.
Related Products / Services
Please note: All products are "FOR RESEARCH USE ONLY AND ARE NOT INTENDED FOR DIAGNOSTIC OR THERAPEUTIC USE"
